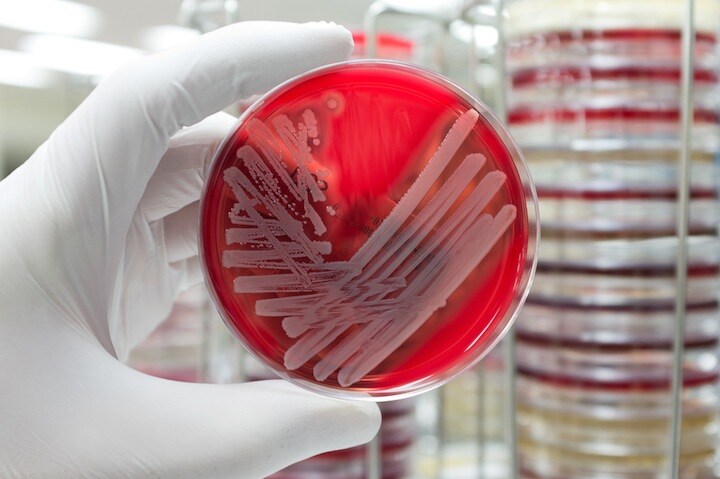
zmeel-iStock

起業家のイーロン・マスク氏が率いる米民間宇宙企業スペースXは2月14日、同社のロケット「ファルコン9」を打ち上げる。ロケットには多剤耐性菌として知られるメチシリン耐性黄色ブドウ球菌(MRSA)を積載し、実験のため国際宇宙ステーション(ISS)に運ぶ予定だ。
米経済メディア「フォーブス」などが報じている。
MRSAとは
メチシリン耐性黄色ブドウ球菌とは、抗生物質のメチシリンに対する薬剤耐性を獲得した黄色ブドウ球菌のこと。黄色ブドウ球菌は、ヒトや動物の皮膚、消化管内などの体表面に常在する菌で、傷口などから体内に侵入した場合に感染症を引き起こし、敗血症、髄膜炎といった重病の原因ともなる。
1940年代に量産に成功した抗生物質ペニシリンが黄色ブドウ球菌の治療に有効だったが、その後ペニシリン耐性株が出現。これに対抗するためメチシリンが開発され、1960年頃から治療に使われるようになったが、まもなくメチシリンにも耐性があるMRSAが確認された(参照:国立感染症研究所「メチシリン耐性黄色ブドウ球菌感染症」)。
シカゴ大学医学MRSA研究所の情報によると、米国では毎年9万人がMRSAの感染症を発症し、約2万人が死亡しているという。
NASAが支援する実験
今回の実験を率いるのは、ナノ生物物理学の権威で、マサチューセッツ州ケンブリッジに拠点を置くナノバイオシム社のCEOを務めるアニタ・ゴエル博士。米航空宇宙局(NASA)が後援する研究の一環で、微重力のISS内の環境でMRSAを培養することにより、菌の突然変異が加速する可能性があるとしている。
NASAは、突然変異のデータを分析することで、「有毒な細菌が薬剤耐性を獲得する仕組みについて知見を得られるとともに、対抗する新薬の開発に役立つことが期待される」と述べている。
ちなみに、スペースXのファルコン9は昨年9月、米フロリダ州ケープカナベラル空軍基地にある発射台で燃焼試験中に爆発している。今回の打ち上げでは、爆破事故を起こしてMRSAをばらまいたりしないことを祈ろう。